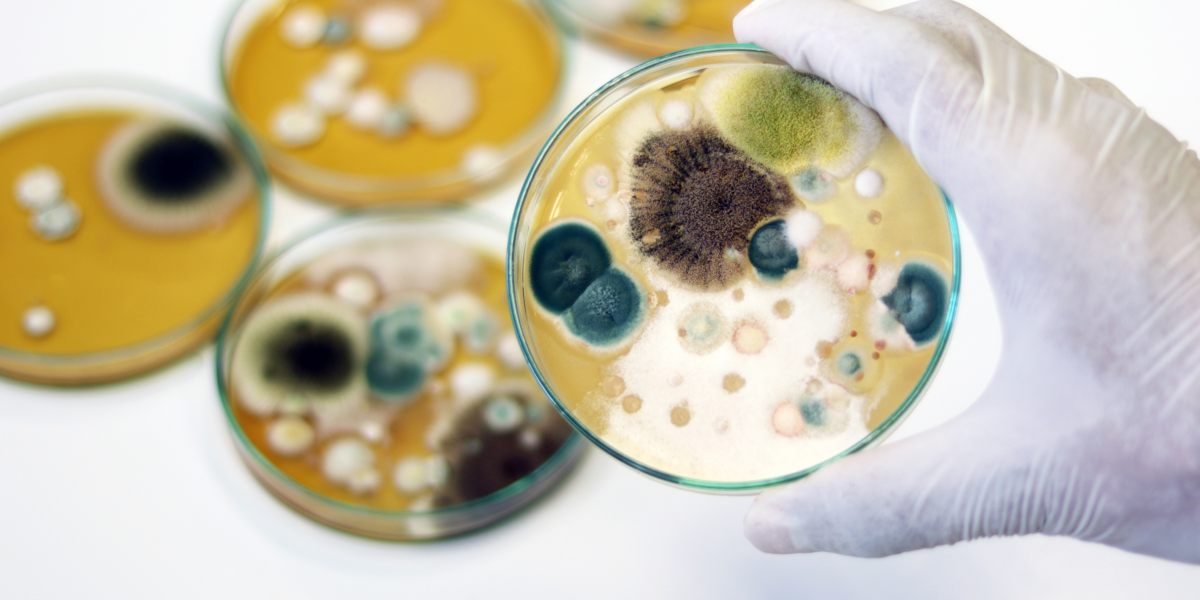

The Dehumanizing Work of Mold
“For Some, Mold Steals Their Humanity” – Mold Toxicity
Daily in our office, we talk about one of my least favorite subjects, mold. Why would I daily spend time talking about or even thinking about something that caused so much harm to my own family? It primarily comes down to the simple fact that my hatred for mold makes me want to fight it wherever I see it’s effects, even in others. So, in a sense, it is a personal battle of vengeance against mold. But it goes beyond that. As I try to walk out my life becoming more and more like Christ according to biblical instruction, I am trying to reflect more and more the image of God in man which he has placed in all of us. I want to help others do that as well, and mold can be one of the most destructive dehumanizers in the physical world.
You see, mold, in some form or fashion, interferes or disrupts most of the basic realities of being human. Each and every effect is not manifested in each and every patient, but ultimately, as a whole, mold works to rob their humanity. Knowing this and knowing how to guide others out of this theft means I spend my days teaching others what is making them sick and how to fight back.
I see the fingerprints of mold when I see patient lives suffering from such thefts of their human nature. In some, this is a theft of their ability to think clearly, remember adequately, or make decisions necessary to care for themselves or others. In some, this is a theft of their ability to feel right, some becoming unexplainably sad, others anxious, others facing extraordinary mood swings, and more. In others, these brain and emotion disruptions steal the joy and fruits of relationships thus harming marriages, friendships, and future generations. In others, theft of normal activities of eating or sleeping lead to an unrelenting thorn, an ongoing struggle, even a daily torment. In still others, their productivity in life is hindered or completely stolen by fatigue, weakness, fear of disabling health “attacks”, and more.
Ultimately, the joys of a healthier, more abundant life feel beyond the reach of those affected by mold. Even their spirits and their faith can be challenged. They can feel less than human. Most of this occurs while they look “normal” on the surface to those around them. Their family and friends and even their medical providers cannot understand why they report such disability. Some around them even doubt they are really sick. This leads to the loneliness and even more loss of their humanity.
Knowing that such an enemy exists and is doing such damage to those in our midst, while knowing that this enemy can be overcome means that I have a responsibility. God has marked my life with the personal experience of that suffering so that I can help set others free. To many with mold toxicity, the idea of a healthier, more abundant life seems out of reach. They just want the thief to return their life, their humanity. If that is you, don’t give up. There is hope. Let us help you restore His image that He placed in you when He created you.
Get started with Sanctuary today!
Click below to schedule your first conversation with our Patient Support Team.
Sanctuary Functional Medicine, under the direction of Dr Eric Potter, IFMCP MD, provides functional medicine services to Nashville, Middle Tennessee and beyond. We frequently treat patients from Kentucky, Alabama, Mississippi, Georgia, Ohio, Indiana, and more... offering the hope of healthier more abundant lives to those with chronic illness.

Dr. Eric Potter graduated from Vanderbilt Medical School and then went on to specialize in internal medicine (adult) and pediatric care, spending significant time and effort in growing his medical understanding while caring for patients from all walks of life.